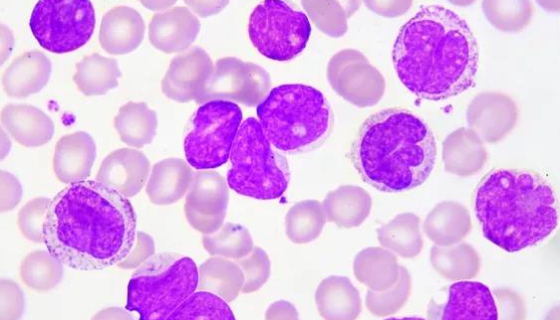
P388小鼠白血病细胞的应用及相关操作！
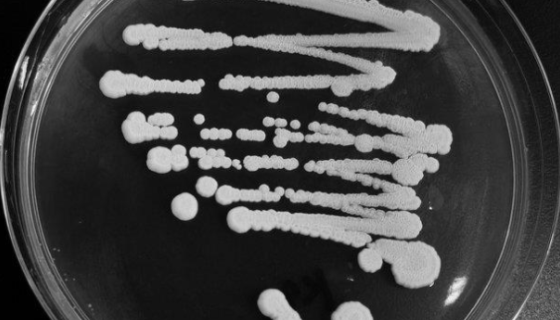
异常威克汉姆酵母的培养方法与使用范围！
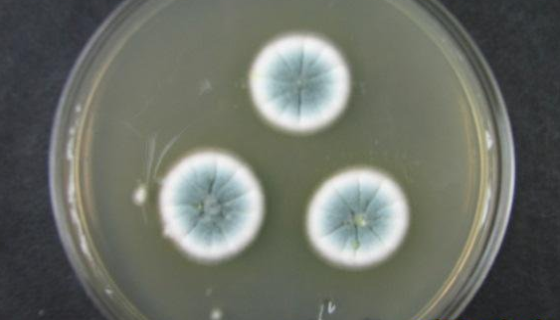
意大利青霉的培养方法及单层冻干管打管说明！

A549+LUC 人肺癌细胞(荧光素酶标记)
人肺癌细胞(荧光素酶标记)接收后的处理方法与培养操作规程及注...

西蒙氏柠檬酸盐培养基的试验方法与注意事项!
西蒙氏柠檬酸盐培养基是一种化学试剂。主要用于柠檬酸盐利用试验...

粪肠球菌的菌株特点与制备方法及其应用!
粪肠球菌(E.faecalis)是革兰氏阳性,过氧化氢阴性球...
P388小鼠白血病细胞的应用及相关操作!
P388小鼠白血病细胞来源于ATCC细胞库是经永生化处理的小...

ATCC 27606 诺维氏梭菌微生物培养方法!
诺维氏梭菌是Clostridium属的微生物,原产地为中国。...
异常威克汉姆酵母的培养方法与使用范围!
异常威克汉姆酵母是Wickerhamomyces属的微生物,...

自然杀伤T细胞的处理方法与培养步骤!
自然杀伤细胞( natural killer cell,NK...

ATCC 8501 变形梭杆菌 百欧博伟生物
变形梭杆菌仅用于科学研究或者工业应用等非医疗目的不可用于人类...
意大利青霉的培养方法及单层冻干管打管说明!
意大利青霉是无性型真菌门 、 半知菌纲、壳霉目、杯霉科中的一...